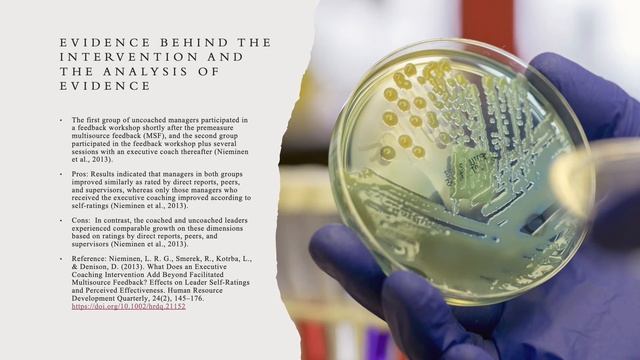
Executive Coaching Intervention Presentation Industrial Organizational Psychology смотреть онлайн

Автор / Канал: Пробуждение мотивации Страница 6

Что делать когда "хреново"?

Четыре цели человеческой жизни

на разных языках, красиво, Алиса Супронова

Почему гражданский брак — не брак?

Управленческое планирование

The Tuckman Model of Team Development | Tuckman Group Stages

МОЯ ПЕДАГОГИЧЕСКАЯ ПОЗИЦИЯ Христюха

тает лёд

Раскраска-антистресс

Для тех кто хочет завоевать весь мир! Для Чего Нужен Актёрский тренинг?

Пьета

Merve Boluğur sokak ortasında sevgilisine bağırdı: Ne diyorsun ya, ne diyorsun?

Introduction to CATHARSIS with Elijah Chai

Catarsis - Jódete en vivo - Alter Rock Puri Fest 2016

Ranking every Dance Gavin Dance album.

Марик Бындю Дин тоатэ инимёара мя

Безнес-леди находит философию своего бизнеса благодаря Коучингу
Executive Coaching Intervention Presentation Industrial Organizational Psychology

Практика со звездами НЛП. Джудит Делозье

Отзыв МК Как жить Яркой жизнью.

Рита Шагиянова, ассистент Coaching Mastery

Видеорубрика: самокоучинг за 1 минуту | планирование

Нейропсихология. Мозг и нервная организация человека

Елена Горелова - впечатления от курса обучения коучингу по стрессоустойчивости и саморегуляции ФИА
За каждым успешным каналом стоит личность, идея и сотни часов кропотливого труда. Если вы здесь, значит, автор «Пробуждение мотивации» уже сумел зацепить ваше внимание своим уникальным стилем или подачей. А мы на RUVIDEO позаботились о том, чтобы вы могли изучить весь архив его работ в максимально комфортных условиях — без лишней суеты и преград.
Почему за работами канала «Пробуждение мотивации» так интересно наблюдать? Всё просто: это честный контент, который находит отклик в сердцах зрителей. На нашем ресурсе вы можете смотреть онлайн все видео любимого автора бесплатно и в хорошем качестве. Нам важно, чтобы вы видели каждую деталь и слышали каждый нюанс, поэтому мы используем только стабильные плееры из открытых источников Rutube.
Следите за новинками канала, пересматривайте старые шедевры и открывайте для себя новые грани творчества «Пробуждение мотивации». Мы постоянно обновляем ленту, чтобы у вас под рукой всегда были самые свежие выпуски. Никаких сложных регистраций — только вы и творчество, которое вдохновляет. Приятного вам путешествия по миру авторского контента на RUVIDEO!
Видео взято из открытых источников Rutube. Если вы правообладатель, обратитесь к первоисточнику.